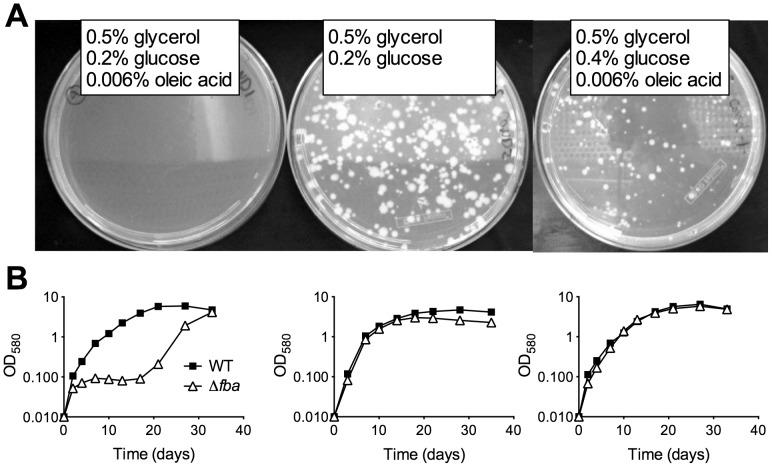
https://cdn.ncbi.nlm.nih.gov/pmc/blobs/25ca/4031216/93a6483c6ba0/ppat.1004144.g003.jpg

果糖-1,6-二磷酸醛缩酶的失活会妨碍结核分枝杆菌中糖酵解和糖异生碳底物的最佳共分解代谢。
Inactivation of fructose-1,6-bisphosphate aldolase prevents optimal co-catabolism of glycolytic and gluconeogenic carbon substrates in Mycobacterium tuberculosis.
作者信息
Puckett Susan, Trujillo Carolina, Eoh Hyungjin, Marrero Joeli, Spencer John, Jackson Mary, Schnappinger Dirk, Rhee Kyu, Ehrt Sabine
机构信息
Department of Microbiology and Immunology, Weill Cornell Medical College, New York, New York, United States of America.
Department of Medicine, Weill Cornell Medical College, New York, New York, United States of America.
出版信息
PLoS Pathog. 2014 May 22;10(5):e1004144. doi: 10.1371/journal.ppat.1004144. eCollection 2014 May.
Metabolic pathways used by Mycobacterium tuberculosis (Mtb) to establish and maintain infections are important for our understanding of pathogenesis and the development of new chemotherapies. To investigate the role of fructose-1,6-bisphosphate aldolase (FBA), we engineered an Mtb strain in which FBA levels were regulated by anhydrotetracycline. Depletion of FBA resulted in clearance of Mtb in both the acute and chronic phases of infection in vivo, and loss of viability in vitro when cultured on single carbon sources. Consistent with prior reports of Mtb's ability to co-catabolize multiple carbon sources, this in vitro essentiality could be overcome when cultured on mixtures of glycolytic and gluconeogenic carbon sources, enabling generation of an fba knockout (Δfba). In vitro studies of Δfba however revealed that lack of FBA could only be compensated for by a specific balance of glucose and butyrate in which growth and metabolism of butyrate were determined by Mtb's ability to co-catabolize glucose. These data thus not only evaluate FBA as a potential drug target in both replicating and persistent Mtb, but also expand our understanding of the multiplicity of in vitro conditions that define the essentiality of Mtb's FBA in vivo.
结核分枝杆菌(Mtb)用于建立和维持感染的代谢途径对于我们理解发病机制和开发新的化疗方法至关重要。为了研究1,6-二磷酸果糖醛缩酶(FBA)的作用,我们构建了一种Mtb菌株,其中FBA水平由脱水四环素调节。FBA的耗竭导致体内感染的急性期和慢性期Mtb的清除,以及在单一碳源上培养时体外活力的丧失。与先前关于Mtb共分解代谢多种碳源能力的报道一致,当在糖酵解和糖异生碳源的混合物上培养时,这种体外必需性可以被克服,从而能够产生fba基因敲除菌株(Δfba)。然而,对Δfba的体外研究表明,只有通过葡萄糖和丁酸盐的特定平衡才能补偿FBA的缺乏,其中丁酸盐的生长和代谢由Mtb共分解代谢葡萄糖的能力决定。因此,这些数据不仅评估了FBA作为复制型和持续型Mtb潜在药物靶点的作用,还扩展了我们对定义Mtb的FBA在体内必需性的体外条件多样性的理解。